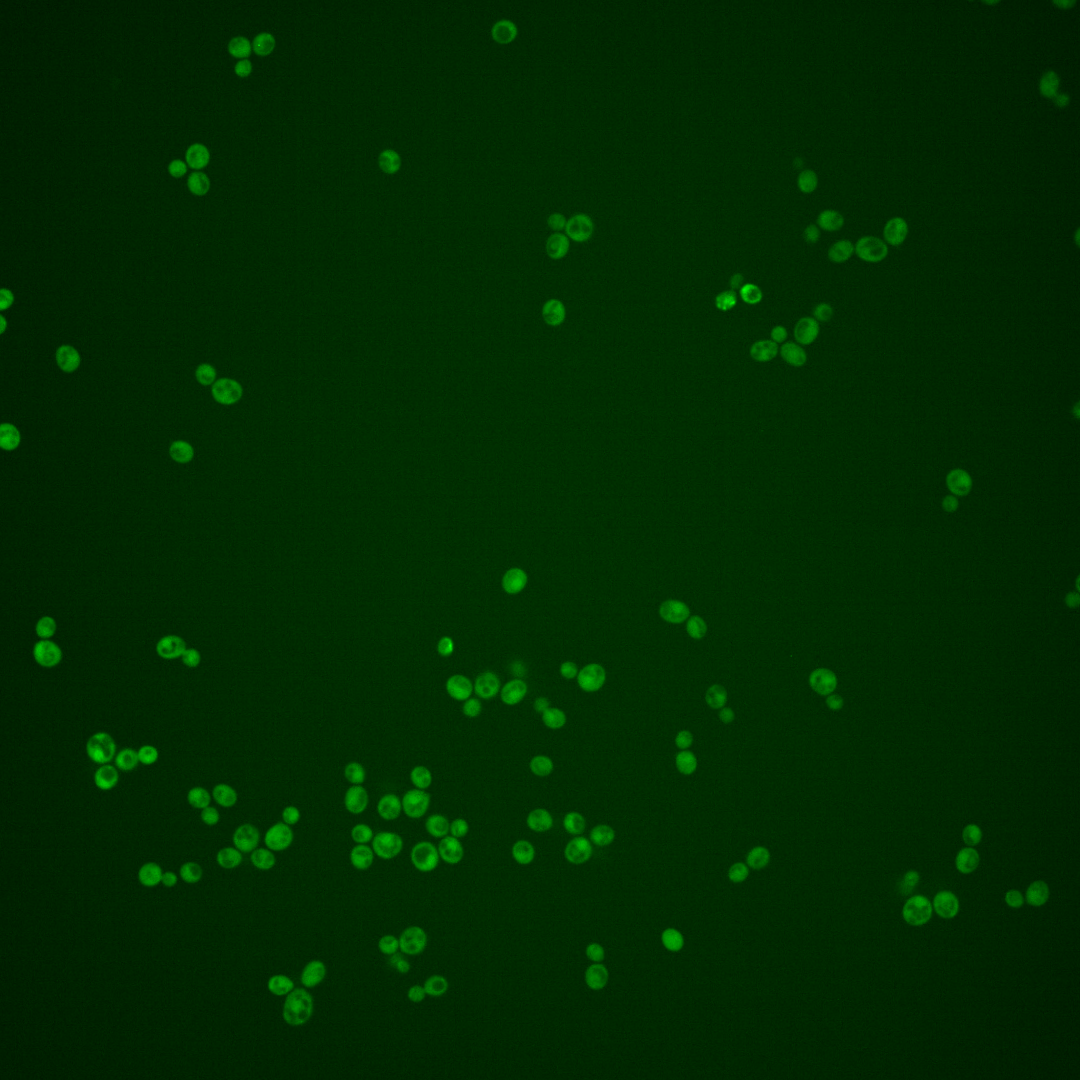
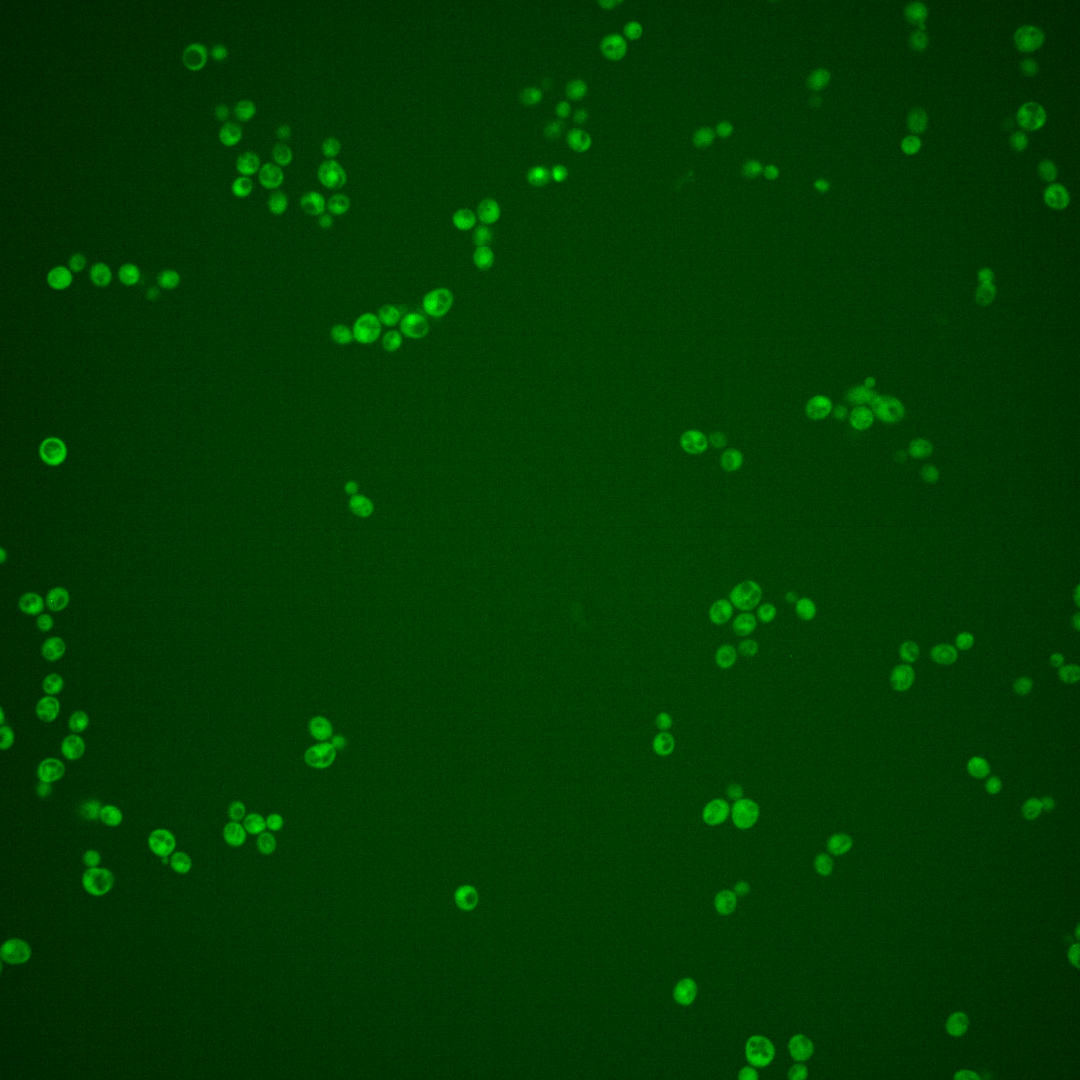
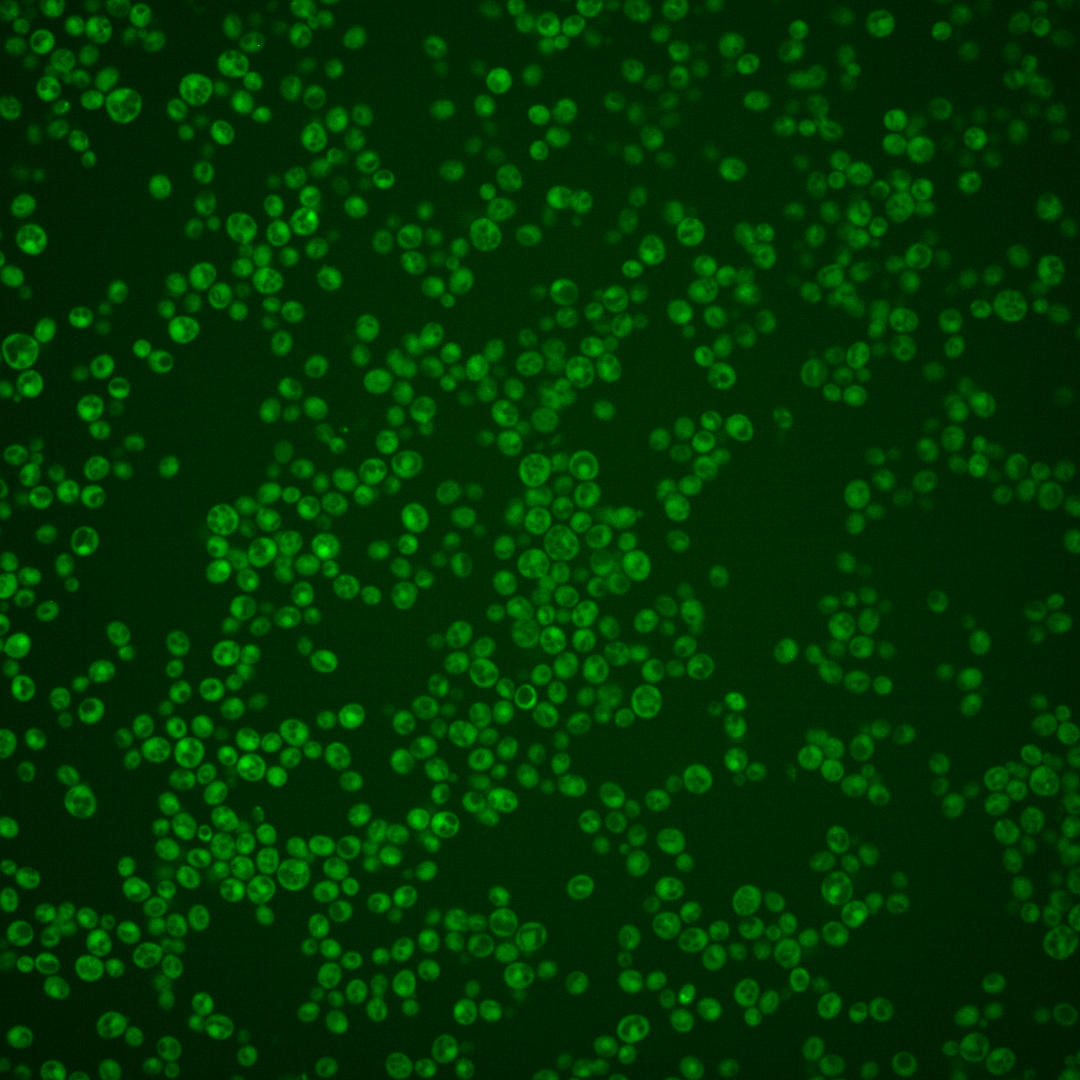

| ORF | |
|---|---|
| Human Ortholog | |
| Description | Putative protein of unknown function; green fluorescent protein (GFP)-fusion protein localizes to the cytoplasm; YGL036W is not an essential gene |
Micrographs




















































































Sub-cellular Localization
Yeast GFP Assignment
Protein Abundance
Localization Change
External localization resources
| ensLOC | DeepLoc | |||||||||||||||||||||||
|---|---|---|---|---|---|---|---|---|---|---|---|---|---|---|---|---|---|---|---|---|---|---|---|---|
| Localization | WT1 | WT2 | WT3 | RAP60 | RAP140 | RAP220 | RAP300 | RAP380 | RAP460 | RAP540 | RAP620 | RAP700 | HU80 | HU120 | HU160 | rpd3Δ_1 | rpd3Δ_2 | rpd3Δ_3 | WT1 | WT2 | WT3 | AF100 | AF140 | AF180 |
| Cortical Patches | 0 | 0 | 2 | 0 | 0 | 0 | 2 | 0 | 1 | – | 0 | 0 | 0 | 0 | 0 | 1 | 1 | 0 | 4 | 4 | 3 | 1 | 8 | 7 |
| Bud | 0 | 1 | 0 | 1 | 0 | 3 | 1 | 2 | 3 | – | 8 | 2 | 1 | 0 | 1 | 0 | 0 | 0 | 3 | 6 | 4 | 3 | 9 | 7 |
| Bud Neck | 0 | 0 | 13 | 2 | 1 | 4 | 7 | 4 | 3 | – | 0 | 1 | 0 | 0 | 0 | 0 | 0 | 0 | 2 | 2 | 0 | 1 | 4 | 1 |
| Bud Site | 0 | 0 | 0 | 0 | 0 | 0 | 1 | 0 | 0 | – | 0 | 0 | 0 | 0 | 0 | 0 | 0 | 0 | – | – | – | – | – | – |
| Cell Periphery | 1 | 4 | 7 | 5 | 4 | 1 | 5 | 2 | 3 | – | 4 | 2 | 2 | 3 | 2 | 41 | 43 | 18 | 0 | 0 | 2 | 0 | 1 | 1 |
| Cytoplasm | 299 | 582 | 577 | 340 | 328 | 349 | 459 | 391 | 351 | – | 200 | 164 | 329 | 296 | 350 | 523 | 487 | 318 | 275 | 555 | 513 | 106 | 181 | 137 |
| Endoplasmic Reticulum | 3 | 6 | 2 | 0 | 1 | 0 | 1 | 0 | 0 | – | 1 | 0 | 0 | 2 | 0 | 11 | 20 | 21 | 0 | 2 | 3 | 10 | 18 | 18 |
| Endosome | 2 | 0 | 0 | 0 | 0 | 1 | 2 | 2 | 0 | – | 0 | 0 | 0 | 0 | 0 | 4 | 3 | 5 | 4 | 10 | 3 | 1 | 18 | 23 |
| Golgi | 0 | 3 | 0 | 0 | 0 | 1 | 0 | 1 | 0 | – | 0 | 0 | 0 | 0 | 0 | 4 | 1 | 2 | 1 | 6 | 0 | 1 | 8 | 8 |
| Mitochondria | 0 | 7 | 1 | 5 | 5 | 18 | 50 | 23 | 106 | – | 97 | 51 | 0 | 0 | 1 | 6 | 4 | 3 | 0 | 10 | 21 | 20 | 52 | 26 |
| Nucleus | 1 | 2 | 4 | 1 | 2 | 0 | 2 | 3 | 1 | – | 1 | 2 | 0 | 2 | 1 | 2 | 2 | 1 | 2 | 0 | 1 | 0 | 0 | 0 |
| Nuclear Periphery | 0 | 2 | 0 | 0 | 0 | 1 | 0 | 0 | 0 | – | 0 | 0 | 0 | 0 | 0 | 0 | 0 | 0 | 1 | 0 | 1 | 0 | 0 | 0 |
| Nucleolus | 0 | 0 | 1 | 0 | 0 | 0 | 0 | 0 | 0 | – | 1 | 0 | 0 | 0 | 0 | 0 | 0 | 0 | 0 | 0 | 0 | 0 | 1 | 0 |
| Peroxisomes | 0 | 0 | 0 | 0 | 0 | 0 | 0 | 0 | 0 | – | 0 | 0 | 0 | 0 | 0 | 0 | 0 | 0 | 0 | 0 | 0 | 0 | 2 | 0 |
| SpindlePole | 1 | 0 | 2 | 0 | 0 | 1 | 1 | 5 | 1 | – | 0 | 2 | 0 | 0 | 1 | 1 | 2 | 2 | 4 | 3 | 4 | 0 | 5 | 3 |
| Vac/Vac Membrane | 0 | 7 | 1 | 1 | 2 | 0 | 3 | 5 | 0 | – | 0 | 4 | 0 | 0 | 2 | 54 | 39 | 24 | 2 | 7 | 5 | 6 | 21 | 20 |
| Unique Cell Count | 305 | 603 | 588 | 341 | 334 | 362 | 490 | 410 | 395 | 250 | 199 | 329 | 299 | 353 | 552 | 516 | 341 | 306 | 616 | 580 | 158 | 342 | 262 | |
| Labelled Cell Count | 307 | 614 | 610 | 355 | 343 | 379 | 534 | 438 | 469 | 312 | 228 | 332 | 303 | 358 | 647 | 602 | 394 | 306 | 616 | 580 | 158 | 342 | 262 | |
Yeast GFP Assignment
Protein Abundance
| Screen | WT1 | WT2 | WT3 | RAP60 | RAP140 | RAP220 | RAP300 | RAP380 | RAP460 | RAP540 | RAP620 | RAP700 | HU80 | HU120 | HU160 | rpd3Δ_1 | rpd3Δ_2 | rpd3Δ_3 | AF100 | AF140 | AF180 |
|---|---|---|---|---|---|---|---|---|---|---|---|---|---|---|---|---|---|---|---|---|---|
| Mean Cell GFP Intensity (1e-4) | 5.4 | 5.8 | 5.5 | 4.8 | 5.6 | 4.3 | 4.6 | 4.9 | 3.9 | – | 3.5 | 4.3 | 5.6 | 5.7 | 5.7 | 8.6 | 8.8 | 7.6 | 5.2 | 5.7 | 6.6 |
| Std Deviation (1e-4) | 1.1 | 1.0 | 1.3 | 1.4 | 1.2 | 1.3 | 0.9 | 1.5 | 0.8 | – | 0.8 | 0.9 | 1.6 | 1.5 | 1.5 | 1.4 | 1.5 | 1.4 | 1.5 | 1.6 | 2.4 |
| Intensity Change (Log2) | – | – | – | -0.19 | 0.02 | -0.36 | -0.26 | -0.16 | -0.5 | – | -0.65 | -0.36 | 0.02 | 0.05 | 0.05 | 0.65 | 0.69 | 0.46 | -0.08 | 0.05 | 0.26 |
Localization Change
| Localization | RAP60 | RAP140 | RAP220 | RAP300 | RAP380 | RAP460 | RAP540 | RAP620 | RAP700 | HU80 | HU120 | HU160 | rpd3Δ_1 | rpd3Δ_2 | rpd3Δ_3 |
|---|---|---|---|---|---|---|---|---|---|---|---|---|---|---|---|
| Cortical Patches | 0 | 0 | 0 | 0 | 0 | 0 | – | 0 | 0 | 0 | 0 | 0 | 0 | 0 | 0 |
| Bud | 0 | 0 | 0 | 0 | 0 | 0 | – | 0 | 0 | 0 | 0 | 0 | 0 | 0 | 0 |
| Bud Neck | 0 | -2.3 | 0 | 0 | -1.5 | 0 | – | 0 | 0 | 0 | 0 | 0 | -3.5 | -3.4 | 0 |
| Bud Site | 0 | 0 | 0 | 0 | 0 | 0 | – | 0 | 0 | 0 | 0 | 0 | 0 | 0 | 0 |
| Cell Periphery | 0 | 0 | 0 | 0 | 0 | 0 | – | 0 | 0 | 0 | 0 | 0 | 5.2 | 5.7 | 3.7 |
| Cytoplasm | 2.1 | 0.1 | -1.6 | -3.8 | -2.5 | -6.2 | – | -9.2 | -8.2 | 2.5 | 1.0 | 1.3 | -3.1 | -3.3 | -3.8 |
| Endoplasmic Reticulum | 0 | 0 | 0 | 0 | 0 | 0 | – | 0 | 0 | 0 | 0 | 0 | 2.6 | 4.2 | 5.5 |
| Endosome | 0 | 0 | 0 | 0 | 0 | 0 | – | 0 | 0 | 0 | 0 | 0 | 0 | 0 | 0 |
| Golgi | 0 | 0 | 0 | 0 | 0 | 0 | – | 0 | 0 | 0 | 0 | 0 | 0 | 0 | 0 |
| Mitochondria | 0 | 0 | 0 | 0 | 5.5 | 0 | – | 0 | 0 | 0 | 0 | 0 | 0 | 0 | 0 |
| Nucleus | 0 | 0 | 0 | 0 | 0 | 0 | – | 0 | 0 | 0 | 0 | 0 | 0 | 0 | 0 |
| Nuclear Periphery | 0 | 0 | 0 | 0 | 0 | 0 | – | 0 | 0 | 0 | 0 | 0 | 0 | 0 | 0 |
| Nucleolus | 0 | 0 | 0 | 0 | 0 | 0 | – | 0 | 0 | 0 | 0 | 0 | 0 | 0 | 0 |
| Peroxisomes | 0 | 0 | 0 | 0 | 0 | 0 | – | 0 | 0 | 0 | 0 | 0 | 0 | 0 | 0 |
| SpindlePole | 0 | 0 | 0 | 0 | 0 | 0 | – | 0 | 0 | 0 | 0 | 0 | 0 | 0 | 0 |
| Vacuole | 0 | 0 | 0 | 0 | 0 | 0 | – | 0 | 0 | 0 | 0 | 0 | 7.6 | 6.6 | 6.2 |
External localization resources
Images






























Protein Concentration and Protein Localization Data
| R1 | R2 | R3 | ||||||||||||||||
|---|---|---|---|---|---|---|---|---|---|---|---|---|---|---|---|---|---|---|
| G1 Pre-START | G1 Post-START | S/G2 | Metaphase | Anaphase | Telophase | G1 Pre-START | G1 Post-START | S/G2 | Metaphase | Anaphase | Telophase | G1 Pre-START | G1 Post-START | S/G2 | Metaphase | Anaphase | Telophase | |
| Concentration | 1.4 | 2.3399 | 1.8704 | 1.9273 | 0.9786 | 2.0763 | 0.894 | 1.4789 | 1.4678 | 1.1165 | 1.9428 | 1.3361 | 1.7405 | 1.461 | 1.3768 | 1.2114 | 1.7356 | 1.6892 |
| Actin | 0.0163 | 0.0002 | 0.0083 | 0.0193 | 0.0002 | 0.0026 | 0.0159 | 0.0012 | 0.0017 | 0.0011 | 0.0406 | 0.0099 | 0.0185 | 0.004 | 0.0118 | 0.0009 | 0.0344 | 0.0393 |
| Bud | 0.0008 | 0.0001 | 0.0014 | 0.0004 | 0 | 0.0001 | 0.0021 | 0.0091 | 0.008 | 0.0134 | 0.0052 | 0.0014 | 0.0496 | 0.0941 | 0.0931 | 0.0547 | 0.1218 | 0.0441 |
| Bud Neck | 0.0019 | 0.0001 | 0.0003 | 0.0023 | 0.0002 | 0.0014 | 0.0045 | 0.0006 | 0.0016 | 0.0015 | 0.0047 | 0.0113 | 0.0098 | 0.0024 | 0.0024 | 0.0029 | 0.0067 | 0.007 |
| Bud Periphery | 0.0032 | 0.0001 | 0.0022 | 0.0006 | 0.0001 | 0.0002 | 0.0074 | 0.0042 | 0.0085 | 0.0078 | 0.0071 | 0.0017 | 0.0279 | 0.0261 | 0.0386 | 0.0265 | 0.0894 | 0.0299 |
| Bud Site | 0.0052 | 0.0004 | 0.0044 | 0.0004 | 0 | 0.0001 | 0.0056 | 0.0363 | 0.0146 | 0.0085 | 0.0143 | 0.0013 | 0.0401 | 0.1503 | 0.0605 | 0.0175 | 0.0235 | 0.0047 |
| Cell Periphery | 0.0016 | 0.0002 | 0.0003 | 0.0002 | 0.0001 | 0.0001 | 0.0005 | 0.0005 | 0.0004 | 0.0004 | 0.0007 | 0.0002 | 0.0021 | 0.0027 | 0.0024 | 0.0007 | 0.0023 | 0.0013 |
| Cytoplasm | 0.1618 | 0.4002 | 0.243 | 0.3068 | 0.5208 | 0.4133 | 0.26 | 0.4365 | 0.3564 | 0.3653 | 0.2894 | 0.4361 | 0.1484 | 0.224 | 0.2089 | 0.1779 | 0.165 | 0.274 |
| Cytoplasmic Foci | 0.0068 | 0.0032 | 0.0114 | 0.0093 | 0.002 | 0.0054 | 0.0285 | 0.0134 | 0.0171 | 0.0204 | 0.053 | 0.0172 | 0.054 | 0.0098 | 0.0189 | 0.0097 | 0.0168 | 0.0281 |
| Eisosomes | 0.0007 | 0.0001 | 0.0003 | 0.0002 | 0 | 0.0001 | 0.0005 | 0.0001 | 0.0001 | 0.0001 | 0.0005 | 0.0002 | 0.0006 | 0.0002 | 0.0003 | 0.0001 | 0.0004 | 0.0002 |
| Endoplasmic Reticulum | 0.0063 | 0.0018 | 0.0015 | 0.0013 | 0.0026 | 0.0015 | 0.0027 | 0.0017 | 0.0013 | 0.0022 | 0.0038 | 0.0016 | 0.0109 | 0.0017 | 0.004 | 0.0014 | 0.0105 | 0.0068 |
| Endosome | 0.0093 | 0.0007 | 0.0025 | 0.006 | 0.0006 | 0.0036 | 0.0198 | 0.0035 | 0.0076 | 0.0066 | 0.0296 | 0.0038 | 0.0241 | 0.0012 | 0.0055 | 0.0014 | 0.0498 | 0.0147 |
| Golgi | 0.0028 | 0.0001 | 0.0021 | 0.0055 | 0.0001 | 0.0008 | 0.0128 | 0.0005 | 0.0009 | 0.0003 | 0.0138 | 0.0006 | 0.0036 | 0.0003 | 0.0008 | 0.0002 | 0.0085 | 0.004 |
| Lipid Particles | 0.0091 | 0.0002 | 0.0082 | 0.0034 | 0 | 0.004 | 0.0179 | 0.0003 | 0.0033 | 0.0003 | 0.038 | 0.0003 | 0.0101 | 0.0005 | 0.0039 | 0.0003 | 0.0054 | 0.0023 |
| Mitochondria | 0.0136 | 0.0001 | 0.0063 | 0.0017 | 0.0001 | 0.0013 | 0.0199 | 0.0007 | 0.0052 | 0.0023 | 0.0245 | 0.0009 | 0.0193 | 0.002 | 0.0048 | 0.0019 | 0.0147 | 0.008 |
| None | 0.7437 | 0.5902 | 0.689 | 0.635 | 0.4726 | 0.5608 | 0.5589 | 0.4784 | 0.5472 | 0.5103 | 0.3331 | 0.5055 | 0.4801 | 0.378 | 0.4084 | 0.5986 | 0.2789 | 0.442 |
| Nuclear Periphery | 0.0048 | 0.0003 | 0.0007 | 0.0003 | 0.0002 | 0.0008 | 0.0053 | 0.0009 | 0.0036 | 0.0028 | 0.006 | 0.0009 | 0.0144 | 0.0049 | 0.0099 | 0.0061 | 0.0282 | 0.0123 |
| Nucleolus | 0.0008 | 0.0001 | 0.001 | 0.0001 | 0 | 0.0001 | 0.001 | 0.0007 | 0.0022 | 0.0036 | 0.003 | 0.0003 | 0.0082 | 0.0052 | 0.0081 | 0.0057 | 0.0088 | 0.003 |
| Nucleus | 0.0016 | 0.0007 | 0.0024 | 0.0004 | 0.0003 | 0.0008 | 0.002 | 0.0046 | 0.0075 | 0.0203 | 0.0061 | 0.0019 | 0.0266 | 0.0498 | 0.0551 | 0.0497 | 0.0626 | 0.0304 |
| Peroxisomes | 0.0033 | 0 | 0.0109 | 0.0052 | 0 | 0.0005 | 0.0285 | 0.0008 | 0.0025 | 0.0005 | 0.0849 | 0.0005 | 0.0089 | 0.0006 | 0.0013 | 0.0005 | 0.0036 | 0.0013 |
| Punctate Nuclear | 0.0032 | 0.0004 | 0.0028 | 0.0005 | 0.0001 | 0.0016 | 0.0025 | 0.0036 | 0.0064 | 0.0275 | 0.0349 | 0.0033 | 0.0282 | 0.0388 | 0.0539 | 0.0403 | 0.0513 | 0.0413 |
| Vacuole | 0.0024 | 0.0006 | 0.0007 | 0.0009 | 0.0002 | 0.0008 | 0.0024 | 0.0022 | 0.0031 | 0.0039 | 0.0055 | 0.0009 | 0.0118 | 0.0031 | 0.0062 | 0.0026 | 0.0114 | 0.0041 |
| Vacuole Periphery | 0.0008 | 0 | 0.0002 | 0.0002 | 0 | 0.0002 | 0.0015 | 0.0002 | 0.0008 | 0.0009 | 0.0013 | 0.0003 | 0.0027 | 0.0005 | 0.0013 | 0.0005 | 0.0063 | 0.0013 |
Sequencing Data
| R1 | R2 | |||||||||
|---|---|---|---|---|---|---|---|---|---|---|
| G1 Post-START | S/G2 | Metaphase | Anaphase | Telophase | G1 Post-START | S/G2 | Metaphase | Anaphase | Telophase | |
| Gene Expression | 15.5608 | 16.2589 | 13.9416 | 27.9964 | 14.1489 | 10.9067 | 21.9192 | 28.725 | 22.5878 | 23.3146 |
| Translational Efficiency | 0.3824 | 0.5062 | 0.6505 | 0.3491 | 0.4199 | 0.61 | 0.4342 | 0.2931 | 0.4436 | 0.3473 |
Hit Data
| Dataset | Hit |
|---|---|
| Protein Concentration | ✘ |
| Protein Localization | ✘ |
| Gene Expression | ✘ |
| Translational Efficiency | ✘ |
Endocytosis
| Temp | Actin Patch (Sac6-tdTomato) | Cortical Patch (Sla1-GFP) | Late Endosome (Snf7-GFP) | Vacuole (Vph1-GFP) |
|---|---|---|---|---|
| 37℃ | ||||
| RT |
Cell Cycle Omics
CYCLoPs (Ygl036w-GFP)
| Gene / Allele | Actin Patch (Sac6-tdTomato) | Cortical Patch (Sla1-GFP) | Late Endosome (Snf7-GFP) | Vacuole (Sac6-tdTomato) |
|---|
| Gene | Images |
|---|
| Gene | Images |
|---|
Images are not yet available
Images are not yet available